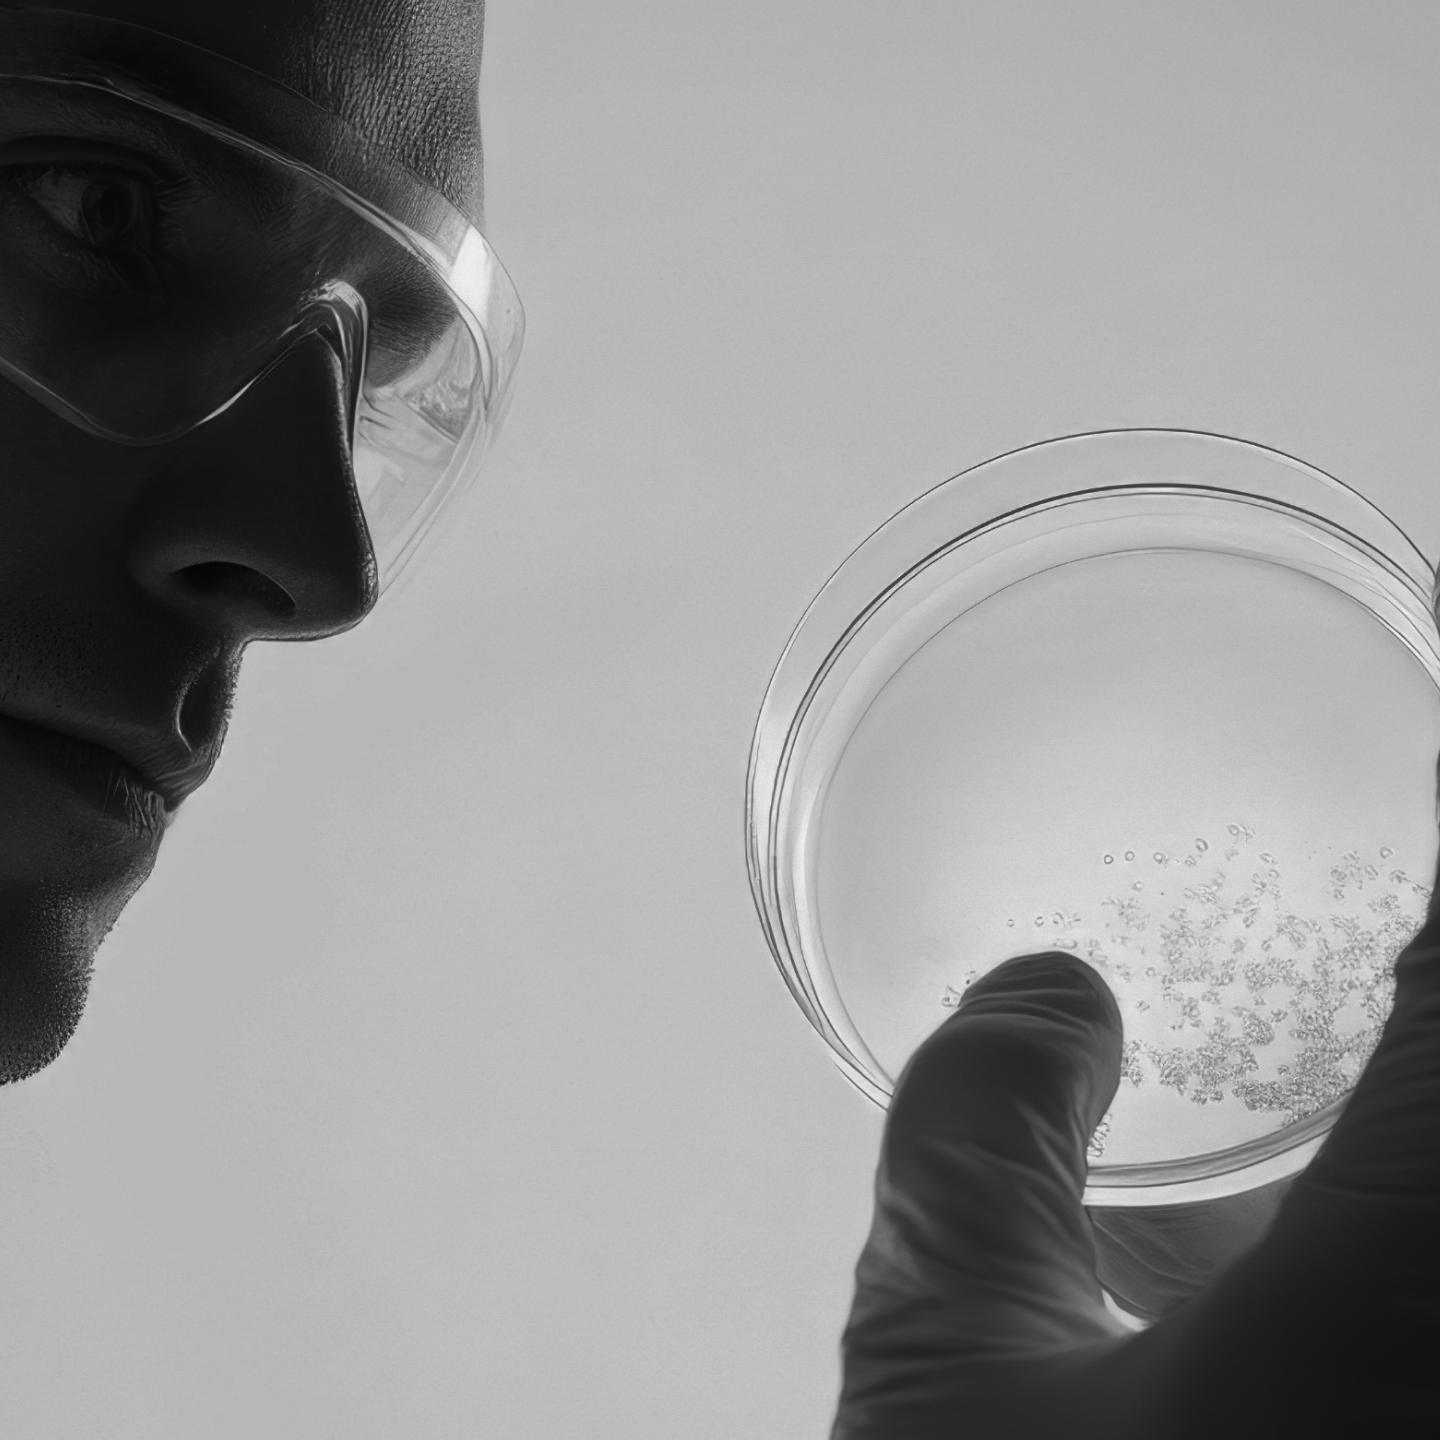

Committed to You.
Skincare shouldn’t overwhelm- it should restore.
At Beyond Beyond, we design purposeful formulations that do more with less. Free from alcohol, parabens, and fragrance, every product is a conscious blend of science-backed ingredients crafted for real, visible results.
Why it matters?
Beyond Buzzwords — A New Standard of Skincare
In a world full of noise, we choose clarity. Beyond Beyond isn’t about trends. It’s about truth: clinically validated, dermatologist-tested, and consciously created skincare that lets your skin thrive naturally.
Our Philosophy

Intentional
Formulation
We use only proven, effective ingredients at functional levels. No fillers. No guesswork.

Clean Clinical
Science
Backed by research, our products bridge skin physiology and clinical-grade actives like NAD+ to deliver results from the inside out.

Small Batch
Craftsmanship
Because your skin deserves the freshest, most potent formulations — never mass-produced.
Ingredient Transparency
Every Ingredient Has a Reason to Be Here.
READY TO RESET YOUR SKIN?
The Ultimate Night Repair Supercream

Discover how intentional, clean clinical skincare can change your relationship with your skin — forever.
No fillers, no shortcuts, just skincare that is honest, effective, and thoughtfully crafted for skin that thrives.







